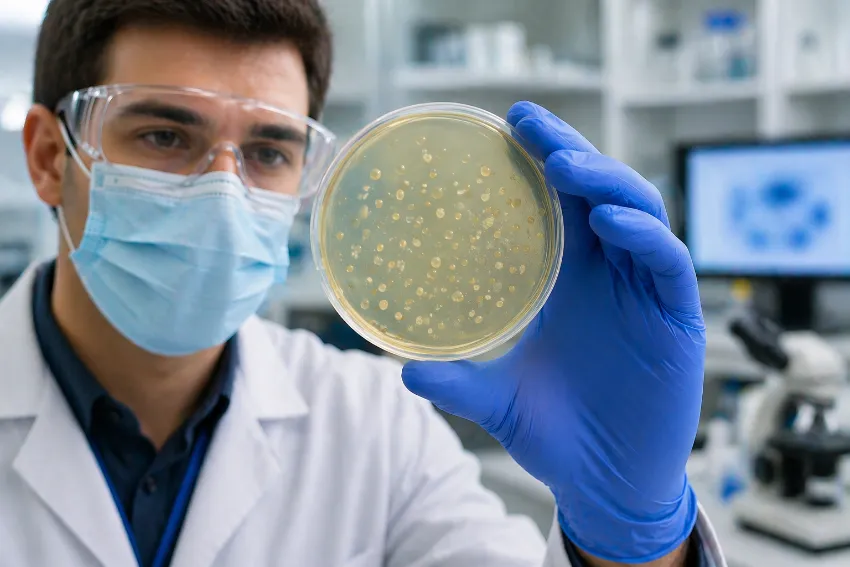
Técnico de laboratorio sujetando Mycoplasma hominis

Como habrás visto en nuestra página web, también realizamos pruebas para detectar estos patógenos, pero estos no son relevantes para todo el mundo.
En este post, te daremos las claves para entender de qué estamos hablando y cuando hay que prestarles atención.
Estos organismos se consideran colonizadores transitorios, es decir, que pueden estar presentes en partes del cuerpo (aquí nos importa la mucosa genital, pero puede estar en el tracto respiratorio o gastrointestinal, por ejemplo) sin causar ningún tipo de síntoma.
M. hominis y los Ureaplasmas forman parte de la flora genital normal de un gran porcentaje de la población sexualmente activa.
En personas con vagina, la colonización en la adultez ronda el 50-80%, mientras en pene (uretra) la colonización aproximadamente un 25% de los casos.
Entonces, si me detectan estas bacterias, ¿debo de recibir tratamiento?
Los estudios científicos no establecen una relación clara de estos organismos y enfermedades genitourinarias. Al ser colonizadores habituales, si aparecen síntomas y estos se detectan, en general, los síntomas se pueden responder por otras causas.
Por tanto, solo deberían ser tratados aquellos pacientes que presenten síntomas y que estos no estén justificados con otras causas más probable.
Además, por la asociación entre estos organismos y las enfermedades pélvicas inflamatorias o complicaciones durante el embarazo, también se puede tratar a aquellas personas que vayan a recibir procedimientos ginecológicos invasivos, estén embarazadas o tengan deseo gestacional.
Por tanto, si te sale positivo en las pruebas, no te preocupes, solo se tratarían si tuvieses síntomas o cumples algunas de estas condiciones.
¿Debo incluir estas pruebas en mis pruebas de ITS?
La respuesta rápida es que sí, pero solamente cuando presentes síntomas. Si estás asintomátic@, tener o no estas bacterias no influye para nada, por lo tanto, en Open House desaconsejamos su cribado en este perfil de paciente.
En Open House, podemos realizar pruebas ultrasensibles para detectar estas bacterias, tenemos un servicio urgente con resultados en máximo 2 horas y otro estándar con resultados en máximo 72 horas laborales.
Si necesitas más información sobre estas bacterias, nuestro equipo médico especialista es la mejor garantía para salir de dudas, llámanos para ampliar información reservar tu cita previa en nuestras clínicas.
Clínica Madrid Clínica Valencia Centro Médico Málaga
Dra. Julieta Domingorena Córdoba

Buen día.
He leído en algunos estudios dicen que ureaplasma urealyticum no es necesariamente una era ya que se ha encontrado también en personas que no han tenido relaciones sexuales antes. Qué tan cierto es esto? Ureaplasma entonces podría ser una bacteria que forma parte de la flora general normal de las personas sin que haya sido contagiada?
Buenas tardes Inés.
Esos estudios son poco concluyentes; a día de hoy la evidencia es que se vincula a gente sexualmente activa.
Si precisases más orientación o continuases con más dudas puedes hacer uso de nuestro servicio de consultas remotas:
https://openhouse.es/test-online/consulta-medica-remota
Un cordial saludo.
Dr. Atef Souied Espada
Director médico
Hola qué tal
Hace aproximadamente 1 año y medio me hice una prueba de mycoplasma y ureaplasma en orina y salí positiva a ureaplasma urealyticum.
Revisé varias fuentes y algunas decían que Ureaplasma puede no considerarse una its ya que puede estar presente en la flora genital de las personas que no necesariamente sean sexualmente activas (no sé qué tan cierto sea esto), pero de todos modos decidí tratarme. Me recetaron azitromicina en 1 sola dosis pero la bacteria seguía presente. Después me recetaron doxicilina por 7 días. Pregunté si debía volver a hacerme la prueba y me dijo la infectologa que no era necesario porque la doxicilina es muy eficiente. Nunca tuve síntomas, y no sé qué tan necesario sería realizarme otra prueba si no he estado con nadie más desde entonces, tomando en cuenta que completé hace 1 año y medio la dosis de doxicilina que me recetaron. Pero sé que en un futuro quisiera embarazarme y tengo miedo de que después de todo ese tiempo la bacteria no se hubiera ido, ya que he leído que puede asociarse con infertilidad.
Buenas tardes Berenice.
Te instamos a que vuelvas a leer el post que figura más arriba ya que ahí queda claro los supuestos en los que se debe tratar.
Si precisases más orientación o continuases con más dudas puedes hacer uso de nuestro servicio de consultas remotas:
https://openhouse.es/test-online/consulta-medica-remota
Un cordial saludo.
Dr. Atef Souied Espada
Director médico
Soy hombre de 60 y pico. Me ha salido positivo en un análisis de its sugerido por mi pareja en ureaplasma parvum y micoplasma hominis sin ningún tipo de molestia ni sintomatología. Mi.pareja es aprensiva y piensa que se le puede pegar por sexo oral porque el vaginal se hace con preservativo. Es eso cierto? Es necesario tratamiento con antibióticos? Y existe riesgo real para un potencial futuro embarazo solo por hacer ese tipo de relación?
Lo primero de todo permíteme saludarte Antonio.
Ureplama parvum, Ureaplasma urealitycum y Mycoplasma hominis son bacterias que pueden formar parte de la flora genital normal en gente sexualmente activa. Sólo se tratan si el paciente tiene síntomas, la pareja sexual habitual del paciente los tiene, tratando a ambos para evitar la reinfección, parejas que están en programas de fecundación in vitro/asistida o personas que se dedican a realizar contenido para adultos y prefieren evitar una transmisión a sus compañeros mediante sexo vaginal desprotegido.
Si no cumples ninguno de estos supuestos desaconsejamos el tratamiento antibiótico.
Si precisases más orientación o continuases con más dudas puedes hacer uso de nuestro servicio de consultas remotas:
https://openhouse.es/test-online/consulta-medica-remota
Un cordial saludo.
Dr. Atef Souied Espada
Director médico
Muchas gracias por la información